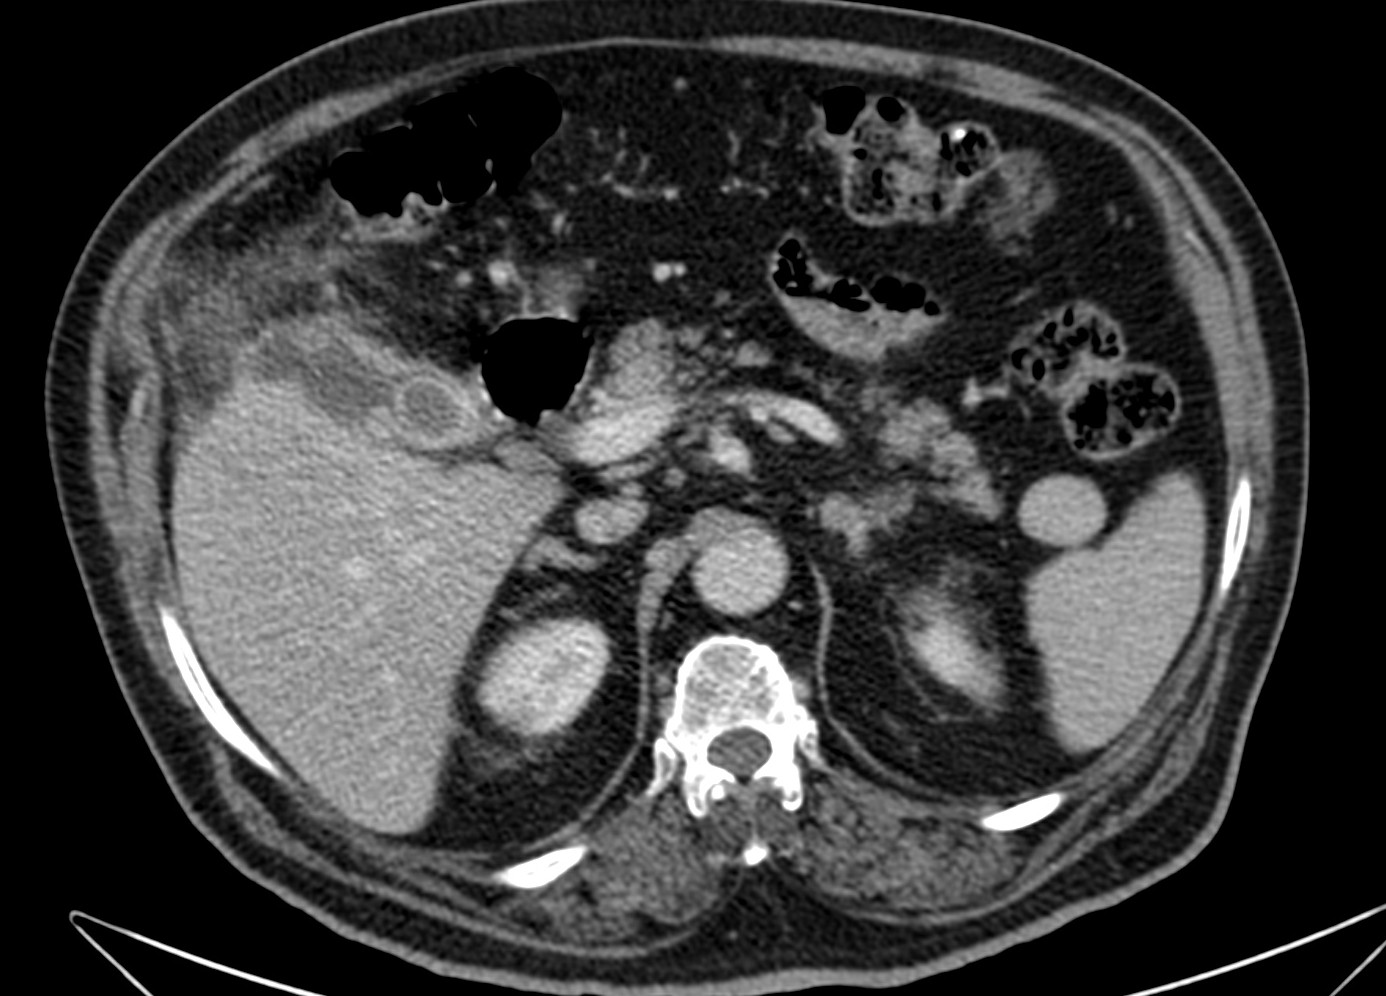

Paciente de 67 años que acude a urgencias con dolor de varias horas de evolución, localizado en epigastrio e hipocondrio derecho. Fiebre de 38,1ºC. Murphy positivo. Analítica: Leucocitosis con neutrofilia.
Se realiza ecografía abdominal:

Con estos hallazgos ecográficos podemos concluir que el paciente presenta una COLECISTITIS AGUDA.
Se realizó posteriormente TC abdominal por mala evolución del paciente:



El paciente, por alto riesgo quirúrgico, recibió tratamiento conservador con antibioterapia. Aún, tras mejoría inical, al cabo de unos días presenta dolor mantenido, fiebre, taquicardia, hipotensión leve y disminución de conciencia. Leucocitosis con neutrofilia.
Se realiza ecografía abdominal:



En sucesivos cortes observamos lo siguiente:



Se observa una mala evolución radiológica. Dada la clínica del paciente y los hallazgos ecográficos podemos concluir que estos hallazgos son compatibles una colecistitis xantunogranulomatosa litiásica sobreinfectada (que se confirmó posteriormente con anatomía patológica).
Se procedió a realizar colecistotomía por US que evidenció la salida de pus y posteriormente se ingresó el paciente en la UCI.
COLECISTITIS AGUDA:
La colecistitis aguda no complicada es la afectación inflamatoria más frecuente de la vesícula biliar. La mayoría de las veces es debida a una obstrucción a nivel del cístico o cuello de la vesícula, la cual finalmente desemboca en colecistitis.
CLÍNICA:
- Mujeres de mediana edad.
- Obesidad.
- Fiebre.
- Dolor persistente de horas de evolución en hipocondrio derecho (HD).
- Náuseas y vómitos.
- Murphy positivo: dolor que corta la inspiración al presionar HD.
- Laboratorio:
- Leucocitosis con neutrofilia (puede o no estar presente)
- Alteración de GPT/GOT, FA y Bilirrubina.
- Elevación de la PCR.
PRUEBAS DE IMAGEN:
RADIOGRAFÍA:
No está sistemáticamente indicada. Es de ayuda para descartar otras enfermedades como una obstrucción intestinal.
ECOGRAFÍA:
Es la técnica de elección para el diagnóstico cuando se sospecha colecistitis (S y E > 95%, Robert et al.).
Criterios ecográficos de colecistitis (No existe consenso generalizado):
– Murphy ecográfico positivo y colelitiasis: es la combinación de signos ecográficos más predictiva de colecistitis aguda (VPP 92%). Puede resultar difícil observa la litiasis si ésta se localiza en el conducto cístico o en el cuello de la vesícula. Con engrosamiento mural el VPP aumenta al 94%)
– Otros signos secundarios son:
- Engrosamiento de la pared vesicular (>4mm) en ausencia de enfermedad hepática crónica, ascitis o insuficiencia cardiaca (el VPP asciende al 94%).
- Líquido perivesicular.
- Imágen de triple pared con capa hipoecoica central.
- Vesícula biliar distendida.
- Aumento de señal Doppler en la pared de la vesícula.
- Presencia de barro o material ecogénico en el interior de la vesícula.
- Gas en la pared vesicular.
Según la guía de Tokyo, el diagnóstico de colecistitis litiásica aguda puede hacerse cuando están presentes al mismo tiempo los siguientes hallazgos: engrosamiento de la pared vesicular mayor de 5 mm, líquido pericolecístico y Murphy ecográfico positivo. Otros signos son distensión vesicular, litiasis biliar, barro o material ecogénico biliar y gas en la pared. Sin embargo, debido a diferencias entre datos de frecuencia de sensibilidad y especificidad de los hallazgos individuales, el diagnóstico debe ser hecho a partir del análisis juicioso de los hallazgos individuales.
OTRAS TÉCNICAS: TC, RM, CPRE-RM.
– La TC se reserva para pacientes con dudas diagnósticas o con discrepancia clínico ecográfica. Se obervarán los mismos hallazgos que en la ecografía, además del aumento de densidad de la pared de la vesícula, del parénquima hepático o especialmente la presencia de otras complicaciones.
– La RM tiene gran sensibilidad para el diagnóstico de la colecistitis aguda, se usa sobre todo para pacientes pediátricos y embarazadas. Los hallazgos son similares a los de la ecografía o TC.
- Colelitiasis: Hipointensidad en T2.
- Engrosamiento mural en T2 y en Fat Sat SC y CC en T1.
- Hiperintensidad del parénquima hepático en Fat Sat CC.
– La CPRE- RM puede mostrar una litiasis impactada (defecto de repleción rodeado por bilis hiperintensa) en el cuello de la vesícula o en el conducto cístico.
TRATAMIENTO:
El tratamiento de una colecistitis aguda no complicada depenede de la situación clínica del paciente y de la institución hospitalaria. Algunos consideran que la inflamación aguda de la vesícula es una contraindicación relativa de la colecistectomía. En tal caso se da antibioterapia iv y se realiza colecistectomía programada cuando el proceso inflamatorio agudo remite. Otros estudios demuestran la eficacia y seguridad de la colecistectomía aguda urgente. En otros casos, cuando la cirugía está contrainicada, puede realizarse colecistotomía percutánea con catéter de drenaje para disminuir la presión intraluminal y con ello el riesgo de perforación. Conviene extraer siempre una muestra de la bilis para su estudio microbiológico.
COMPLICACIONES DE LA COLECISTITIS:
- Empiema: también denominada colecistitis supurativa, se produce cuando la vesícula se llena de material purulento y se distiende su lumen. Los pacientes pueden presentar los mismos síntomas de una colecistitis aguda no complicada. Los signos de sepsis pueden estar o no presentes.
- Tanto en ecografía como en TC, los hallazgos por imagen son inespecíficos y son similares a los que se encuentran en una colecistitis no complicada.
- El barro biliar y el pus son indistiguibles tanto en eco como en TC; en RM si podría diferenciarse en secuencias T2.
- Colecistitis enfisematosa: es la presencia de gas en el interior de la vesícula sin fistulización al tracto GI. Más frecuente en pacientes de edad avanzada, diabéticos, se produce por la isquemia o falta de aporte sanguíneo a la vesícula. Clostridios, Escherichia coli, S. Aureus, Streptococos son los gérmenes más frecuentes.
- Radiografía: con baja S. Lucencias curvilíneas en HD.
- Ecografía: hiperecogenicidad curvilínea que puede tener artefacto de reverberación o cola de cometa.
- TC: prueba más S y E. Se ven zonas de baja densidad que corresponden al gas en la pared o intraluminal.
- RM: zonas de baja intensidad en la pared o lumen.
- Colecistitis hemorrágica: puede darse en el contexto de una colecistitis calculosa o acalculosa. Además de los signos de colecistitis, puede existir hematemesis o melena y ha de diferenciarse de otras causas de sangrado vesicular como las debidas a trauma, neoplasia o coagulopatía.
- Eco y TC: mostrarán, además de los signos de colecistitis, material ecogénico/heterogéneo (eco) o hiperdenso (TC) en el interior de la vesícula. También puede ser dificil diferenciarlo del barro, la RM puede sacarnos de dudas (alteraciones de la intensidad en T1 y T2 por el paramagnetismo del la metahemoglobina).
- Colecistitis acalculosa: se observa en paciente muy cirticos o en UCI. La bilis aumenta de densidad y obstruye el cístico.
- Eco y TC: los hallazgos son los comunes a la colecistitis aguda, aunque incluyen con más frecuencia líquido pericolecístico o afectación del parénquima hepático; aunque existe ausencia de litiasis.
- RM: no se suele usar por la situación inestable del paciente.
- Colecistitis crónica: suelen existir antecedentes de colecistitia aguda, cólicos biliares o tambén puede darse en asintomáticos. Hay falta de motilidad vesicular. El Helicobacter Pylori podría constituir un factor de riesgo. Suelen existir engrosamiento mural y litiasis, la vesícula puede estar contraída o engrosada y la inflamación pericolecística suele estar ausente. En ocasiones se usa la medicina nuclear para diferenciar la inflamación aguda o crónica de la vesícula y la motilidad. Pueden darse complicaciones como perforaciones, carcinoma o fístulas con producción de íleo biliar.

- Colecistitis xantunogranulomatosa: nódulos o bandas intramurales. Se producen por la oclusión de los senos de Rokitansky Aschoff de la pared, los cuales se rompen, luego la bilis coloniza la pared y finalmente produce una reacción inflamatoria a la que puede sobreañadirse una infección. Es un factor de riesgo para el carcinoma.
- Eco y TC: Litiasis + engrosamiento mural focal o difuso. Puede haber cambios inflamatorios pericolecísiticos. Los nódulos hipocogénicos o bandas pueden sugerir el diagnóstico específico de c. xantunogranulomatosa.
- El diagnóstico raramente se realiza previo a la cirugía y al análisis histopatologíco.

- Sd. de Mirizzi: se produce una obstrucción del cuello de la vesícula o del cístico y se produce una colestasis. La distensión de la vesícula o la inflamación pericolecística obstruyen el conducto hepático común, produciendo edema y fibrosis. Suele existir ictericia +/- dolor, fiebre o leucocitosis.
- Eco y Tc: litiasis impactada con dilatación del conducto hepático común. Cambios inflamatorios y engrosamiento mural.
- El conducto hepático común puede tener un calibre normal.
- RM y CPRE – MR pueden ayudar a distinguir el Sd de Mirizzi de otras causas de ictericia obstructiva.
- Hepatitis aguda: pacientes con colecistis aguda pueden experimentar cambios clínicos y analíticos compatibles con hepatitis.
- Existe una correlación directa entre el nivel de elevación de las transaminasas y el engrosamiento mural de la vesícula.
- Imagen: cambios inflamatorios de una colecistitis + edema en parénquima hepático e hiperecogenicidad del lobulillo portal (triada portal).
- Vólvulo de vesícula: infrecuente y de dificil sospecha, puede exisitir reciente e importante pérdida de peso. Suele darse en mujeres de edad avanzada (60 – 80 años). La vesícula puede sufrir una rotación completa o incompleta (<180º). La volvulación puede derivar en una isquemia con posterior gangrena y perforación.
- En eco y TC puede observarse la ausencia de vesícula en su lecho habitual junto con cambios inflamatorios de la misma y región adyacente.
- La colelitiasis puede estar ausente.
- CPRE: puede ser de ayuda al mostrar el giro del cístico y la distensión de la vesícula.
- Colecistitis gangrenosa y perforación: asociada con una gran mortalidad, se distingue por:
- Eco: núcleos o membranas intraluminales ecogénicas con sombra, disrupción de la pared vesicular y abscesos pericolecísticos. Estrias en la pared o alternancia de líneas hipo e hiperecogénicas.
- TC: alta E, baja S. Gas mural, falta de realce mural, membranas intraluminales, abscesos pericolecísticos, estriación mural, hiperdensidad del parénquima hepático adyacente.
- Puede derivar en una perforación sobre todo del fundus con extravasación del contenido vesicular si la perforaciónon no es contenida.
- Otras complicaciones: Absceso subfrénico, pancreatitis aguda, íleo biliar, fístula biliar externa o interna, colangitis.


Bibliografía:
Cross-Sectional Imaging of Acute and Chronic Gallbladder Inflammatory Disease
Acute biliary disease: initial CT and follow-up US versus initial US and follow-up CT.
Protocolo diagnóstico del paciente con dolor en fosa iliaca izquierda. HRU Málaga.
Deja un comentario